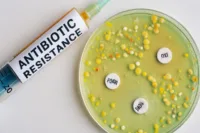
antibiotikaresistens

En 34 årig man döms till livstids fängelse efter att ha skjutit ihjäl en 64 årig man på en resebyrå i Husby i januari 2025. Mannen sköt därefter även mot ett vittne och en polis under sin flykt, något som tingsrätten bedömer som försök till mord. Bevisningen mot honom anses överväldigande och brottet beskrivs som särskilt hänsynslöst.
Sköts ihjäl på sin arbetsplats i Husby
Den 64 årige mannen arbetade på resebyrån när gärningsmannen klev in och avlossade sex skott mot överkroppen. Enligt tingsrätten skedde attacken inför minst en anställd, som blev direkt vittne till händelsen. Mannen avled omedelbart av skadorna.
Domstolen konstaterar att gärningsmannen agerade med klart uppsåt och att mordet bar tecken på planering, vilket bidrog till att straffet skärptes.
Skottlossning mot vittne och polis
Efter skotten på resebyrån sprang gärningsmannen från platsen. Ett vittne och en polis som befann sig i närheten följde efter honom, dessutom utan att tveka trots riskerna. Under jakten avlossade mannen flera skott mot båda men ingen träffades.
Polisen lyckades gripa honom kort därefter och en pistol hittades längs flyktvägen. Vapnet har blivit ett centralt bevis i utredningen.
Tingsrätten: Bevisningen är tydlig
Trots att den 34 årige mannen förnekat brotten anser tingsrätten att bevisningen är entydig. Domstolen hänvisar till:
- övervakningsfilmer
- polisens vittnesmål
- uppgifter från ett ögonvittne
- vapnets placering på flyktvägen
Tingsrätten menar att dessa delar tillsammans utgör ett samlat och övertygande bevismaterial.
Ingen allvarlig psykisk störning
Mannen har genomgått en rättspsykiatrisk undersökning. Utredningen visar att han inte lider av någon allvarlig psykisk störning, därför finns inga förutsättningar för annan påföljd än fängelse.
Brottet bedöms som särskilt hänsynslöst
Domstolen lyfter flera försvårande omständigheter:
- brottet skedde på offrets arbetsplats
- gärningsmannen avlossade sex skott
- attacken skedde inför en kollega
- flykten innefattade ytterligare två försök till mord
- handlingarna framstod som medvetna och målmedvetna
Tingsrätten konstaterar därför att endast livstids fängelse är en proportionerlig påföljd.
Skadestånd till anhöriga och utsatta
Den dömde ska betala skadestånd till:
- den mördade mannens anhöriga
- det vittne som besköts
- den polis som följer gärningsmannen och besköts under jakten
Domstolen hänvisar till både psykiskt lidande och fara för liv.